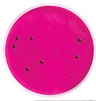
MXSMEND48.jpg

MILLIFLEX MEIO M ENDO LES AGAR COLIFORMES CONF. STD METHODS VALIDADE MINIMA: 3 MESES (CX) MILLIPORE
Modelo: MXSMEND48
R$ 3.995,71
ou até 3x de R$ 1.331,90 sem juros
Economize 5% no PIX: R$ 3.795,92
ou 3,5% no boleto: R$ 3.855,86
